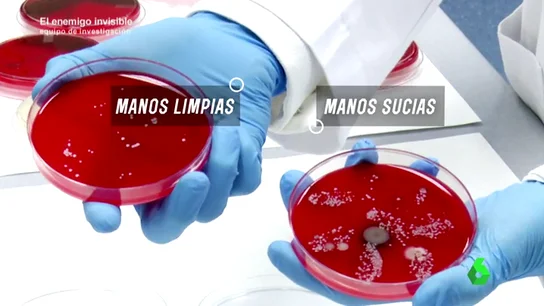
Frame 168.900999 de: BACTERIAS ESCONDIDAS Frame 168.900999 de: BACTERIAS ESCONDIDAS

UNA AMENAZA QUE YA ES UNA REALIDAD
Las superbacterias, resistentes a todos los antibióticos: "En 2050 causarán más muertes que el cáncer"
Las bacterias son el organismo más abundante de nuestro planeta. Menos en la sangre y en el cerebro, se reparten por todo el cuerpo y son imprescindibles para la vida pero algunas se han vuelto casi invencibles.